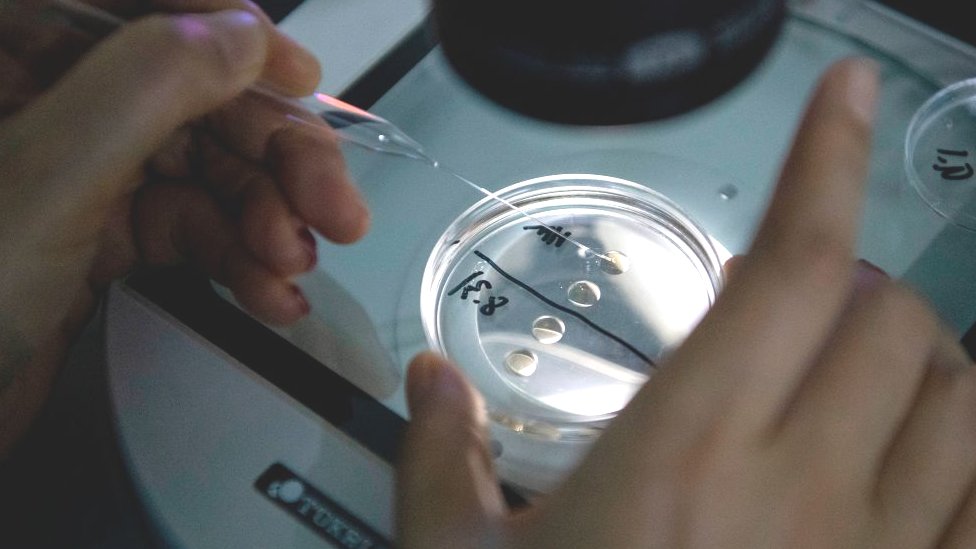

Kad je voljeni kućni ljubimac dobio dijagnozu neizlečivog raka, Džon Mendole je odlučio da ga klonira.
Mendola je penzionisani njujorški policajac.
Bio je na dužnosti 2006. godine u policijskoj stanici na Long Ajlendu kad mu je doveden mali, ofucani pas lutalica.
„Bila je sva ućebana, niste mogli ni da je iščetkate… i imala je pokvarene zube, ali je bila apsolutno ljupka i zahvalna", kaže on.
Završivši smenu toga dana, Mendola je kolegama poručio da nema potrebe da vode životinju belo-smeđeg krzna u azil jer će je on odneti kući.
„Bila je to najbolja odluka u mom životu", kaže ovaj pedesetdvogodišnjak.
Spašeni pas, ukrštena vrsta po imenu ši apso, obožavao je decu i igru.
Mendola ju je nazvao Princeza po brojnim junakinjama Diznijevih animiranih filmova.
- Ovca Doli: Klon koji je promenio nauku i svet
- Da li su svinje budućnost presađivanja organa
- Šta su „ljudske himere“ i kako je Japan postao prva zemlja koja dopušta naučnicima da ih uzgajaju

Deset godina kasnije, 2016, godine, veterinar mu je saopštio loše vesti - Princeza je imala rak.
Mendola je odmah pozvao teksašku kompaniju Viagen Pets end Ekvin, prvu i jedinu američku firmu koja nudi komercijalno kloniranje pasa i mačaka.
Kaže da je znao za proces zato što je gledao južnokorejski dokumentarac o ovoj temi.
Azijska zemlja je vodeća na tom polju i proizvela je prvog kloniranog psa 2005. godine.
Viagen je uzeo biopsiju, iliti uzorak tkiva od Princeze, pre nego što je uginula 2017. godine.
Iz tog genetskog materijala rođena su dva klona od surogat pseće majke godinu dana kasnije.
Štenci su bili genetski identični Princezi.
Mendola ih je nazvao Princeza Arijel i Princeza Jasmin, kao još jednu posvetu Diznijevim filmovima.
„Šare, dlaka, sve je prilično isto, čak i maniri", kaže on.
„Znate kako psi ponekad ustanu i protresu čitavo telo? Obe to rade istovremeno, baš kao što je to Princeza radila."
Kloniranje kućnih ljubimaca je kontroverzno, ali postaje sve popularnije uprkos neprestano visokoj ceni.
Iz Viagena kažu da kloniraju „sve više i više ljubimaca svake godine" i da su ih klonirali „stotine" otkako su počeli s radom 2015. godine.
Firma naplaćuje 50.000 dolara (oko 45.000 evra) za kloniranje psa, 30.000 dolara (27.000 evra) za mačku i 85.000 dolara (77.500 evra) za konja.
Ta cena je očigledno nedostupna većini, ali veliki broj slavnih ličnosti obelodanio je poslednjih godina da su klonirali njihove pse ili da planiraju to da učine.
Barbra Strajsend se poverila da je koristila usluge Viagena da bi klonirala dva šteneta njene pokojne kućne ljubimice Samante.
Iste godine, list San pisao je o tome kako je muzički mogul i sudija na takmičenjima za talente Sajmon Kauel „stoprocentno klonirao" njegova tri jorkširska terijera.

Postoji veliki broj konkretnih tehnika kloniranja, ali najčešće se ćelijsko jedro životinje koju želite da klonirate ubrizga u jajnu ćeliju davaoca čiji je genetski materijal uklonjen.
Jajna ćelija se potom gaji tako da izraste, u laboratoriji, u embrion.
Embrion se posle toga implantira u matericu surogat majke koja rađa štene, mače ili ždrebe.
Blejk Rasel, predsednik Viagena, kaže da genetski materijal životinje koju želite da klonirate može da se pohrani maltene na neodređeno vreme pre nego što se pokrene proces kloniranja.
To je tako zahvaljujući veoma niskim temperaturama zamrzavanja iliti kriptoprezervaciji.
„Klonirani kućni ljubimac je, jednostavno rečeno, identični genetski blizanac, razdvojen godinama, decenijama, možda vekovima", dodaje on.
Njegova kompanija tvrdi da je „posvećena zdravlju i blagostanju svakog psa i mačke sa kojima radi" i da se strogo pridržava svih propisa u SAD.

A opet su organizacije za zaštitu životinja zabrinute zbog ovog sektora.
Na primer, veliki broj naučnih studija ukazuje na to da su klonirane životinje sklonije bolestima.
Drugi kritičari ističu veliki procenat neuspeha u ovoj industriji - veliki broj klonova se ne rađa zdrav i prav.
Jedan izveštaj iz 2018. godine njujorškog Univerziteta Kolumbija procenjuje da je stopa uspeha svega 20 odsto.
To znači da su vam potrebne mnoge surogat majke da biste mogli da imate više pokušaja.
Peni Hokins, stručnjakinja za dobrobit životinja iz Kraljevskog društva za prevenciju svireposti prema životinjama, kaže da ume da bude bolno i naporno za ženke životinja kojima se uklanjaju jajne ćelije za doniranje, kao i za one životinje koje se pripremaju za surogat trudnoću.
Uz to, klonirana životinja nikad neće biti identična kopija prvobitne životinje, najviše u pogledu njenog ponašanja.
„Životinja je mnogo više od njene puke DNK, a klonirane životinje će neizbežno imati drugačija životna iskustva, što će za posledicu imati životinje sa drugačijom ličnošću."
Čak je i predstavnik Viagena prošle godine izjavio da 25 odsto ličnosti životinje potiče od njenog odrastanja ili odgoja.

Doktorka Hokins dodaje: „Preporučili bismo svakom ko traži novog ljubimca da postane deo njegove porodice da usvoji jednu od hiljade životinja u azilima koji traže stalni dom."
Elisa Alen, direktorka grupe za zaštitu prava životinja „Ljudi za etički tretman životinja" (PETA), takođe želi da ljudi uzimaju spašenog psa umesto kloniranog.
„Ličnost životinja, njihove osobenosti, njihova suština, naprosto ne može da se ponovi", kaže ona.
„A kad shvatite da milioni predivnih, lako prilagodljivih pasa i mačaka trune po azilima za životinje svake godine ili umire na stravične načine pošto budu napušteni, shvatite da kloniranje doprinosi krizi prekomernog broja životinja bez doma.
„PETA poziva svakoga ko traži da uvede još jednog životinjskog saputnika u život da ga usvoji iz lokalnog azila umesto da podržava kloniranje, svirepu modu na kojoj se zarađuje novac."
Genetičar Endrju Hesel, s druge strane, tvrdi da kloniranje stvara vrlo malo etičkih problema, ako se obavlja odgovorno.
„Neko bi mogao da kaže: 'Zašto klonirati životinje kad imate sve te druge životinje spremne za usvajanje?'", kaže on.
„A opet, istu stvar biste mogli reći i za ljudsku decu.
„Zašto imati vlastitu decu kad imate svu tu decu spremnu za usvajanje? I kućni ljubimci takođe postanu članovi porodice."
- Genetsko modifikovanje: Zašto je bitno
- Princeza ili superheroj - lična karta za pronalaženje ljubimaca
- Ekscentrične rase pasa koje su nestale
Na Long Ajlendu, Mendola kaže da su Princeza Arijel i Princeza Jasmin zdrave i srećne.
Pre nego što je prvobitna Princeza uginula, usvojio je još jednog spašenog psa po imenu Bibi.
„Kad sam doneo novu štenad kući, Bibi ih je momentalno zavolela", kaže on.
„Nedostajala joj je Princeza. Onjušila ih je i bila srećna. One su bile Princeza."
Bibi je neočekivano uginula prošle godine, ali Mendola se već pripremio - sačuvao je njen genetski materijal za potencijalno buduće kloniranje.
Dodatno izveštavanje: urednik feljtona Nova ekonomija Vil Smejl.
Pratite nas na Fejsbuku, Tviteru i Vajberu. Ako imate predlog teme za nas, javite se na bbcnasrpskom@bbc.co.uk
Pogledajte još:
Preuzmi aplikaciju i prati vijesti
PRATITE NAS NA






